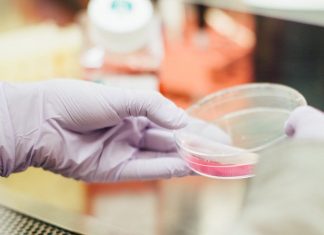

Research reveals “extensive network” of industry ties with healthcare
Results document pathways for potential influence across the system; better oversight needed to preserve public trust in healthcare, say researchers
The medical product industry maintains...
Research finds excess use of non-emergency restraint among older psychiatric patients
Restrictive interventions like acute control medications and restraints are more likely to be used in non-emergency situations among older psychiatric inpatients than younger ones,...
New research finds TNF inhibitor more effective with regular serum assessment to adjust dose
New research presented this week at ACR Convergence, the American College of Rheumatology’s annual meeting, shows that proactive therapeutic drug monitoring, a newer treatment...
New research finds racial gaps in renal complications persist for children with Lupus
New research presented this week at ACR Convergence, the American College of Rheumatology’s annual meeting, found that while hospitalized children with juvenile lupus have...
New Study: Pandemic underlines need to address physician burnout
Two out of three Vancouver physicians surveyed in a new UBC study faced burnout during the COVID-19 pandemic.
Researchers from UBC’s faculty of medicine reviewed...
Study: Concerns about judgement of autistic adults
Autistic adults can be wrongly perceived as deceptive and lacking credibility, Flinders University researchers say, with this working against many caught in the legal...
Study: The many ways the Sexual Violence Resource Centre offers help
In order to fulfill the commitment to maintaining a safe and respectful work and learning environment, the University of Manitoba actively listens to the...
Study: Babies’ random choices become their preferences
When a baby reaches for one stuffed animal in a room filled with others just like it, that seemingly random choice is very bad...
Study: Data tool helps users manage water resources, protect infrastructure
River systems are essential resources for everything from drinking water supply to power generation - but these systems are also hydrologically complex, and it...
Study: Significant decline in prescription opioid abuse seen among Americans at last
Almost 20 years into the opioid epidemic, there finally is evidence of significant and continual decreases in the abuse of these risky pain medications,...